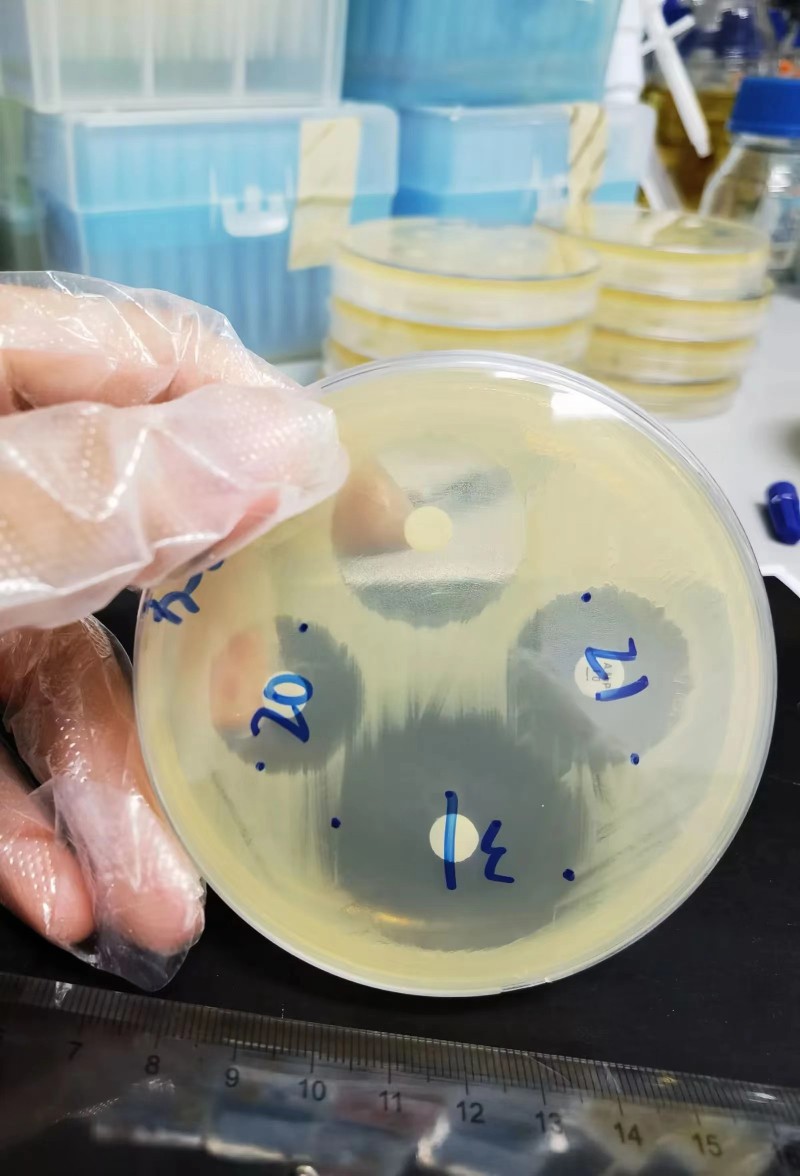
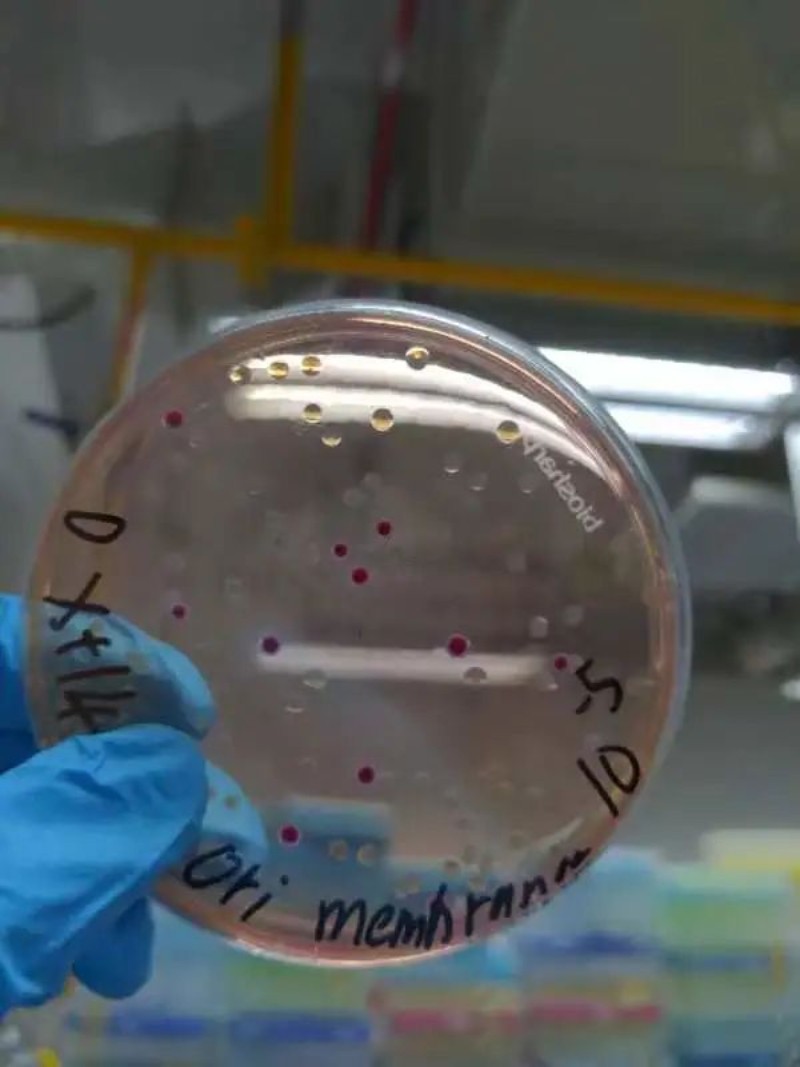

发布日期:10/5/2022
在行业内磨练专业技能
在课题组学习科研知识
在志愿活动中传递爱心
这个暑期
广以人用自己的方式
诠释属于理工人的精彩
基因技术公司
@2020级郑雁桐
这个假期我有幸在基因技术公司进行为期一个月的暑期实习,我实习的岗位是产品研发和微生物检验。我的主要任务是和师姐一起探索实验条件,研发出最贴近客户需求的产品,并对产品进行相关的微生物检测。

通过这一个月的实习,我收获了很多。一方面我学会将学校学习到的理论知识应用到工作中,另一方面我感觉自己实验实操能力得到了很大提升。在学校因为时间限制,实验器材准备工作都是由教授或者学长学姐们帮忙做好的。而这次实习,则需要自己提前预估好实验所需器材并拿去灭菌,所以对实验操作过程也会更加熟悉。除此之外,我发现通过查阅文献对实验方案进行不断改善的过程挺有意思的。在一次次修改实验方案并探索出想要得到的实验状态后会有满满的成就感。

这次实习我也很感谢老师和同事的关心帮助,让我渡过了一个充实且收获丰富的一个月!
医学检验所
@2019级卓煜钊
今年暑假,我顺利通过了简历筛选及面试,前往广州一家医学检验所进行实习。检验所坐落于广州官洲生物岛,是一家以肿瘤基因测序,癌症早检为主的医学检验公司。

由于我是尚未本科毕业的实习生,所以暂时不允许接触核心实验,只能进行比较前端的工作。一开始我主要负责样品接收,在接样室接收各种DNA、血液、新鲜组织、切片等样本,并进行初步检测。后来,我被安排到样本管理室工作。独自一人在一间有数十台-80°C超低温冰箱的实验室里储存和废弃样品。我需要按照要求以及保存标准,将PAX血浆、DNA、RNA、红细胞和白细胞封膜并储存,以及将切片按要求废弃,同时进行登记。每天还需在各个实验室之间流转DNA、血液、蜡块等样品。日常的工作非常繁忙。

一开始我并没有适应这么高强度且重复度极高的工作,在接样室有时候一站就是一早上,经常犯困。后来慢慢习惯了,变得更加有耐心,更能在高强度的工作下保持专注。之后被安排到单独的实验室,也慢慢的开始适应孤独以及繁重的工作。相比于专业方面,这两个月的实习对我个人素养以及抗压能力提升方面帮助更大,也让我又一次体验到了科研的艰辛。

说点题外话,这家公司是NGS方面的领头羊,作为实习生能享受到公司中秋节的福利,平时上下班也有专车接送到地铁口,每周能有三天的假。生物岛上既有无人驾驶的小巴,也有无人早餐售卖车,还有自动巡逻的机器人,很多大型科技型企业也落户于生物岛上。这次的实习让我体会到除了研究领域和岗位匹配度,这些公司规模、福利、环境等“软实力”上的优点也同样重要。
食品研发公司
@2019级李奕篁
这个暑期,怀揣着对未知的忐忑不安,我前往本地一家食品研发公司进行实习。公司规模不算大,各个部门都是紧密连接在一起的。技术中心由实验室、品管部、研发部组成,由此来保障安全生产。

带我的师姐工作能力非常出色,任何繁琐细节都能够考虑到。从早上配置溶液开始,到车间例行采样,取每天需要检测的食品并进行分样,然后洗平板,写记录,最后进入微检室涂布平板,这么多步骤她都可以有条不紊的完成。当我遇到不清楚的地方,她在百忙之中还是会很细心的教我,实验室主管和其他同事也经常在工作上给予我帮助。在大家的帮助下,我很快掌握了工作流程,适应了工作环境,高质量地完成工作任务,也得到了领导和同事的认可。

这次的实习让我顺利拿到了人生之中第一桶金,体验到了学习之外完全不同的生活,学会了如何和社会上的人们打交道,明白了在外如何主动去学习,同时也感受到赚钱的不易。平时我们总是抱怨说在学校学到的知识运用不到实践之中,但是在这段实习里,如何将样品接种到平板上,如何涂布平板,数平板,用什么样的培养基培养什么类型的细菌或者致病菌,都是我们曾经在学校学习并实践过的。有的时候从学校学到的知识可能并不能完全照搬到生活工作之中,但是从中学到的方法是通用的,并且能让我们一直受益。

我不是潮汕人,也听不懂潮汕话。原本我以为不能融入这个圈子,但是一起工作,一起筹备中秋晚会,一起进行团建,这些日日夜夜的相处竟让我与他们融为一体。刚来公司时我觉得一个月太难熬,日子过得慢,现在我竟然觉得时间过得太快了。我开始留恋这个地方,留恋我的同事们。我想我肯定会记住你们的吧。

食品研发公司
@2020级欧永圳
这个暑假我在一家食品研发公司进行了为期一个月的实习,这是一家涉及植物提取物及其综合利用品研发的企业。作为一名化学工程专业的学生,我实习的主要工作是对公司生产出来的各种产品及反应中间体进行检验分析。在这次实习中,我将平时在课堂中学习到的理论运用到实践中去,更加清楚地了解了书本上知识的在工业生产中的具体应用。


我还利用周末休息的时间,继续锻炼自己的摄影技能,做到工作兴趣两不误。


广以科研课题组
@2020级李晖泓
这个暑期,我在梁嘉言老师的项目组上学习,在他的博士生指导下开展实验。暑假的第一阶段的是进行菌的耐药测试,所以每天都可以看到这样的“米老鼠”。

现在进行的是蔬菜种植,以及一些菌的接合实验。

虽然大部分时间都“住”在实验室,但能学习到新的东西以及做科研的态度,也便十分满足开心。很感谢梁嘉言老师,让我能够接触到自己喜欢的东西,比如生物信息学。在项目组的实验之余,我还自学了生物信息学相关的软件,协助翻译完成我们项目的提案,掌握了怎么用BioRender(一种科研制图工具)绘图。

总而言之在项目组的每一天都过得十分充实。
三下乡志愿活动
这个假期,还有这样一批人,他们在广东以色列理工学院团委带领下参加龙湖区呼援通社工服务中心开展的公益志愿活动,为辖区户籍长者提供量血压、传播防诈骗知识等一些力所能及的协助,送上大学生对老年人的一份关怀,传播志愿者精神。


冬季学期将至,希望大家能带着假期满满的收获,开启新一轮的广以生活!
